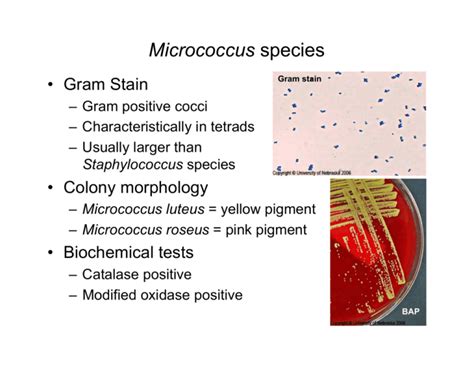

Micrococcus Species: Understanding And Treating Infections
Micrococcus Species: Understanding and Treating Infections
Hey everyone! Today, we’re diving deep into the world of Micrococcus species , a group of bacteria that, while often harmless, can sometimes cause a bit of trouble. We’ll explore what they are, where you might find them, and most importantly, how we deal with infections they might cause. So, grab your virtual lab coats, guys, because this is going to be an interesting ride!
Table of Contents
What Exactly Are Micrococcus Species?
Alright, so let’s get down to business. Micrococcus species are Gram-positive cocci, which basically means they’re round-shaped bacteria that show up as purple when you stain them in a lab. They’re everywhere – seriously, you can find them on human skin, in soil, dust, water, and even on animals. They’re part of the normal flora for many of us, meaning they hang out on our bodies without causing any harm. Think of them as tiny, microscopic roommates who usually keep to themselves. They’re known for being pretty tough, able to survive in a wide range of environments, including those with high salt concentrations or radiation. This resilience is one of the reasons they’re so widespread. In the grand scheme of microbiology, Micrococcus belongs to a family that includes other well-known bacteria, but Micrococcus itself is distinguished by its unique cellular division pattern, where daughter cells often remain clustered together in tetrads or irregular masses. This characteristic arrangement is a key feature for identification under a microscope. Their metabolic pathways are also quite interesting; they’re typically aerobic, meaning they need oxygen to grow, and they’re catalase-positive, which is another crucial diagnostic marker used by scientists. The genus Micrococcus is quite diverse, with several species identified, though Micrococcus luteus is the most commonly encountered one in clinical settings. It’s fascinating how these seemingly simple organisms have evolved to thrive in such diverse niches, from the sterile environments of medical equipment to the bustling ecosystems within our own bodies. Understanding their basic biology is the first step in appreciating how they can sometimes transition from benign inhabitants to opportunistic pathogens. We’ll delve into how this transition happens and what we can do about it.
When Micrococcus Becomes a Problem: Infections
Now, the million-dollar question: when do these ubiquitous bacteria actually cause problems? Generally, Micrococcus species are considered opportunistic pathogens. This means they don’t usually infect healthy individuals. Instead, they tend to strike when our immune system is compromised or when there’s a breach in our body’s natural defenses. Think about situations like surgery, where the skin barrier is broken, or in individuals with weakened immune systems due to conditions like HIV, cancer, or chemotherapy. In these cases, Micrococcus can take advantage of the situation and invade deeper tissues, leading to infections. These infections can manifest in various ways, ranging from minor skin and soft tissue infections, like boils or wound infections, to more serious conditions such as bacteremia (bacteria in the bloodstream), endocarditis (infection of the heart valves), meningitis (infection of the membranes surrounding the brain and spinal cord), and even pneumonia. The severity really depends on the individual’s health status and the site of infection. For instance, a small cut on an otherwise healthy person might just get a localized Micrococcus infection that’s easily treated. However, for someone with a serious underlying illness, the same bacteria entering their bloodstream could potentially lead to life-threatening sepsis. It’s important to remember that Micrococcus is often found alongside other bacteria, like Staphylococcus , which can make diagnosis a bit trickier. Sometimes, Micrococcus might be present in a sample simply because it’s part of the normal skin flora that got collected during the procedure, rather than being the actual cause of the infection. This is why clinical correlation is super important – doctors and lab professionals need to look at the whole picture: the patient’s symptoms, their medical history, and the lab results together to figure out what’s really going on. The rise of antibiotic resistance is also a growing concern with Micrococcus infections, just like with many other bacterial pathogens. While traditionally susceptible to many common antibiotics, strains are emerging that show resistance, necessitating careful monitoring and appropriate treatment strategies. This underscores the need for ongoing research into effective treatment protocols and potential alternative therapies to combat these resilient microbes.
Diagnosing Micrococcus Infections
So, how do doctors figure out if it’s really Micrococcus species causing the trouble? The diagnostic process usually starts with a clinical suspicion based on the patient’s symptoms and medical history. If a doctor suspects a bacterial infection, they’ll likely collect a sample from the affected area. This could be a swab from a wound or skin lesion, blood, urine, or even cerebrospinal fluid, depending on where the infection is thought to be. These samples are then sent to a microbiology laboratory for analysis. In the lab, the first step is usually a Gram stain. As I mentioned earlier, Micrococcus are Gram-positive cocci, and seeing them clustered in characteristic tetrads or irregular masses on the Gram stain is a strong clue. However, it looks very similar to Staphylococcus under the microscope, so further tests are needed for definitive identification. The next crucial step is culturing the bacteria. The sample is placed on a special growth medium, and if Micrococcus is present and viable, it will multiply, forming visible colonies. Different species of Micrococcus can have distinct colony appearances, like the yellow pigment produced by Micrococcus luteus , which can help in preliminary identification. Once colonies are observed, various biochemical tests are performed. These tests assess the bacteria’s metabolic capabilities, such as their ability to produce certain enzymes or utilize specific sugars. For example, the catalase test is a classic one; Micrococcus species are strongly catalase-positive, meaning they produce an enzyme that breaks down hydrogen peroxide, causing bubbles. This helps differentiate them from some other Gram-positive bacteria. Other tests might include oxidase tests, tests for pigment production, and tests for susceptibility to certain antibiotics. Advanced techniques like MALDI-TOF mass spectrometry (Matrix-Assisted Laser Desorption/Ionization-Time of Flight mass spectrometry) are now widely used in clinical labs. This method can rapidly identify bacteria, including Micrococcus species, by analyzing the protein profile of the bacterial cells, offering a much faster and often more accurate identification compared to traditional biochemical methods. It’s a real game-changer in speeding up the diagnostic process, allowing for quicker treatment decisions. Furthermore, if the infection is suspected to be in the bloodstream or a deep tissue, blood cultures are essential. Detecting Micrococcus in a blood culture, especially in significant numbers or in conjunction with clinical signs of infection, is a strong indicator of bacteremia. The interpretation of lab results always needs to be done in context with the patient’s clinical presentation to distinguish between colonization (the bacteria being present but not causing disease) and true infection. This careful, multi-step approach ensures accurate diagnosis, which is paramount for effective Micrococcus species treatment .
Treatment Options for Micrococcus Infections
When it comes to Micrococcus species treatment , the approach really depends on the severity and location of the infection, as well as the patient’s overall health. For minor skin and soft tissue infections, often caused by Micrococcus luteus , treatment might be as simple as good wound care, including cleaning the affected area and applying topical antiseptics or antibiotic ointments. In many cases, especially in healthy individuals, the body’s own immune system can clear these minor infections without the need for systemic antibiotics. However, if the infection is more widespread, deeper, or if the patient is immunocompromised, oral or even intravenous antibiotics will likely be prescribed. Thankfully, Micrococcus species have historically been susceptible to a range of common antibiotics. Penicillin was once a go-to treatment, but due to increasing resistance, other agents are now frequently used. Commonly prescribed antibiotics include:
- Cephalosporins: Drugs like cephalexin (Keflex) are often effective, especially for skin infections.
- Macrolides: Erythromycin, azithromycin (Zithromax), and clarithromycin can be used, particularly if there’s a penicillin allergy.
- Tetracyclines: Doxycycline is another option that shows good activity against many Micrococcus strains.
- Clindamycin: This is often effective and can be useful for certain types of skin and soft tissue infections.
- Vancomycin: For severe infections, especially those involving resistant strains or bloodstream infections, vancomycin might be administered intravenously.
It’s absolutely crucial to complete the entire course of antibiotics as prescribed, even if you start feeling better. Stopping early can lead to the infection returning or contribute to the development of antibiotic resistance. Antibiotic susceptibility testing is a key part of Micrococcus species treatment . The lab will perform tests to determine which specific antibiotics are most effective against the particular strain of Micrococcus causing the infection. This ensures that the prescribed treatment is targeted and has the best chance of success. For more severe conditions like endocarditis or deep-seated infections, a longer course of treatment, often involving intravenous antibiotics, is necessary. In rare cases, surgical intervention might be required, for example, to drain an abscess or remove infected tissue. Prevention is also a big part of managing Micrococcus species treatment , especially in hospital settings. Strict hygiene practices, proper wound care, and careful handling of medical devices can all help minimize the risk of these bacteria causing infections in vulnerable patients. The rise of antibiotic resistance is a significant challenge, and researchers are constantly looking for new ways to combat bacterial infections, including exploring alternative therapies like phage therapy or new antimicrobial compounds. But for now, judicious use of existing antibiotics, guided by susceptibility testing, remains the cornerstone of effective treatment.
Prevention Strategies
Preventing Micrococcus species infections largely boils down to good hygiene and maintaining a strong immune system. Since these bacteria are all around us, eradicating them completely isn’t really feasible or even desirable, as they play a role in our natural microbial balance. However, we can significantly reduce the risk of them causing problems, especially in vulnerable individuals or healthcare settings. Key prevention strategies include:
- Hand Hygiene: This is probably the single most important measure, guys! Frequent and thorough hand washing with soap and water, or using alcohol-based hand sanitizers, is critical. This is especially important for healthcare workers, who are constantly exposed to various microbes, and for anyone caring for someone with a compromised immune system or open wounds. Think about it: if you touch a contaminated surface and then touch your eyes, nose, or mouth, or an open wound, you’re providing a direct entry point for bacteria.
- Proper Wound Care: Keeping cuts, scrapes, and surgical incisions clean and covered is vital. Regularly changing bandages and ensuring the wound area is free from dirt and debris helps prevent bacteria like Micrococcus from entering and multiplying. For individuals prone to infections, antiseptic solutions might be recommended for cleaning wounds.
- Strengthening the Immune System: A robust immune system is your best defense. This involves maintaining a healthy lifestyle: eating a balanced diet rich in fruits and vegetables, getting adequate sleep, managing stress, and engaging in regular physical activity. For patients undergoing treatments that suppress the immune system (like chemotherapy), doctors often take extra precautions and may prescribe prophylactic antibiotics or other measures to prevent infections.
- Environmental Cleaning and Disinfection: In healthcare facilities and even in homes where vulnerable individuals reside, regular cleaning and disinfection of surfaces and medical equipment are essential. This helps reduce the overall bacterial load in the environment. This includes things like bed rails, doorknobs, and shared living spaces.
- Judicious Use of Antibiotics: While antibiotics are crucial for treating infections, their overuse or misuse can lead to the development of antibiotic resistance. It’s important that antibiotics are only used when truly necessary and prescribed by a healthcare professional based on proper diagnosis. This applies to both human and animal medicine.
- Screening and Surveillance: In some high-risk settings, screening individuals for carriage of certain bacteria might be considered, although this is less common for Micrococcus compared to other pathogens like MRSA. However, surveillance for Micrococcus infections in hospitals can help identify outbreaks or trends in antibiotic resistance.
By implementing these measures consistently, we can significantly lower the chances of Micrococcus species causing infections and help keep ourselves and others healthy. It’s all about being proactive and aware of how we can minimize risks in our daily lives and in clinical practice.
The Future of Micrococcus Treatment
Looking ahead, the landscape for Micrococcus species treatment is evolving, driven by the persistent challenge of antibiotic resistance and the need for more targeted therapies. While many Micrococcus strains remain susceptible to traditional antibiotics, the emergence of resistant strains necessitates continuous research and development. One key area of focus is understanding the mechanisms behind antibiotic resistance in Micrococcus . By identifying the specific genes and pathways involved, scientists can develop strategies to overcome or circumvent this resistance. This might involve creating new drugs that target these resistance mechanisms or using combination therapies that are more effective against resistant bacteria. Another promising avenue is the exploration of alternative antimicrobial strategies . Phage therapy, which uses bacteriophages (viruses that specifically infect and kill bacteria), is gaining renewed interest. Phages are highly specific, meaning they can target pathogenic bacteria without harming beneficial microbes, and they have a lower propensity to induce resistance compared to antibiotics. Developing personalized phage cocktails tailored to the specific Micrococcus strain could offer a powerful treatment option, particularly for chronic or difficult-to-treat infections. Antimicrobial peptides (AMPs) , naturally occurring molecules found in many organisms, are also being investigated. These peptides can disrupt bacterial cell membranes and exhibit broad-spectrum antimicrobial activity, often with different mechanisms of action than conventional antibiotics, making them potentially effective against resistant strains. Furthermore, research into adjunctive therapies is ongoing. This involves using non-antibiotic agents in combination with traditional antibiotics to enhance their efficacy or reduce toxicity. Examples include compounds that inhibit bacterial biofilm formation, as biofilms can make bacteria more tolerant to antibiotics, or agents that boost the host’s immune response to help clear the infection. Probiotics and prebiotics are also being explored for their potential role in modulating the host’s microbiome and preventing or managing bacterial infections, though their direct application in treating active Micrococcus infections is still an area of research. Ultimately, the future of Micrococcus species treatment will likely involve a more personalized and multi-faceted approach. This means leveraging advanced diagnostics to rapidly identify the specific pathogen and its resistance profile, employing a combination of conventional and novel therapeutic agents, and considering the patient’s individual immune status and microbiome. The goal is to move beyond a one-size-fits-all approach towards precision medicine in infectious disease management. Continuous surveillance for resistance patterns and ongoing research into novel treatment modalities will be critical to stay ahead of these resilient bacteria and ensure effective Micrococcus species treatment for years to come. Stay curious, stay healthy!